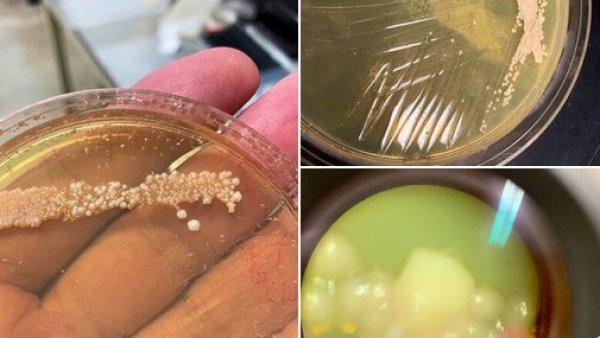
4500 yıllık maya ile ekmek pişirdi

Fizikçi ve video oyunu tasarımcısı Seamus Blackley, Antik Mısır üzerine çalışmalar yürüten Serena Love ve mikrobiyolog Richard Bowman’la ABD'nin Massachusetts eyaletinde bir araştırmada çalıştığı sırada, Antik Mısır’dan kalma bir çanaktan, maya kalıntılarını çıkarıp topladığını söyledi.

"NORMAL EKMEKTEN DAHA ZENGİN VE TATLI"
Numunelerin kapların gözeneklerinden toplandığını, ancak organizmaları uyandırmadan önce bir sterilizasyon tekniği kullandığını anlatan Blackley, mayaya daha sonra yağ ve su eklediğini, pişirildiğinde 'harika bir aromayla güzelce kabardığını' söyledi.

Deneyiminin sonuçlarını sosyal medyadan paylaşan Blackley, pişirdiği ekmeğin normal ekmeklerden daha ‘zengin ve tatlı’ olduğunu söyleyip ekledi:
"Ancak yenmesinin uygun olup olmadığını onaylamak için örnekler daha çok araştırılmalı."

ESKİ MISIRLILAR GİBİ PİŞİRMEK İSTİYOR
Blackley, "Bu proje Mısır bilimi ve ekmek pişirme sevgimden doğdu. Mısırlıların çok sevdiği ekmeği tekrar yaratabileceğimi fark ettim.” dedi.
"Eğlence ve deneme için bu ekmek normal mayalı ekmeğin pişirildiği fırında pişirildi. Ancak Mısırlılar gibi pişirmek için önümüzdeki birkaç ay için gerekli aletleri geliştiriyoruz." diyen Blackley, “İşlem çok karmaşık, çünkü bu değerli örnekleri kirletmeden toplamamamız gerekiyor.” ifadelerini kullandı.
"NUMUNE SAF DEĞİLDİ"
Blackley, “Bunun sadece deneme için olduğunu unutmayın. Numune saf değildi ve iyi analiz edilmedi. Bu yüzden önümüzde daha çok iş var.” şeklinde konuştu.
Blackley, Love ve Bowman’ın örnekleri gelecek sene analiz edeceklerini de söyledi.
